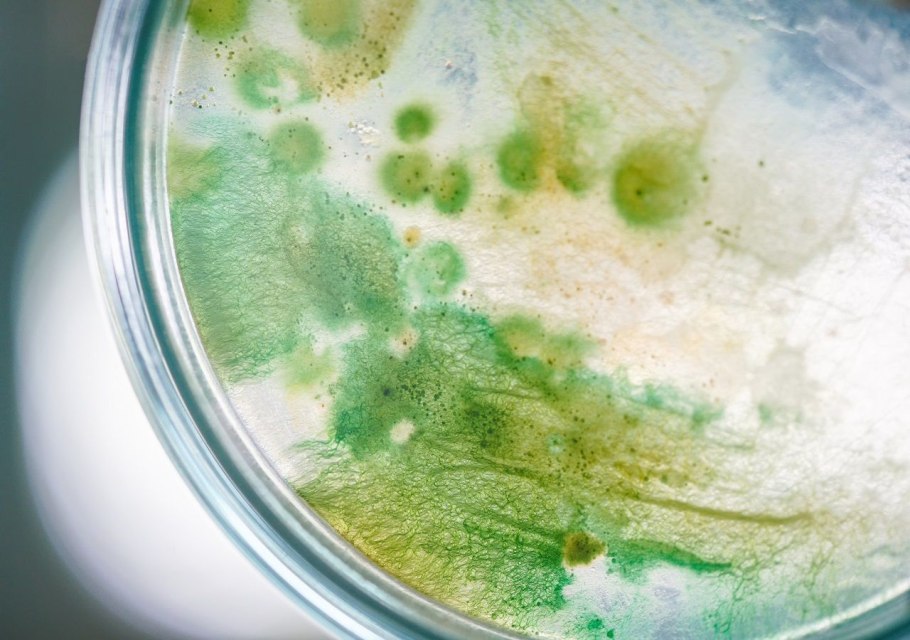
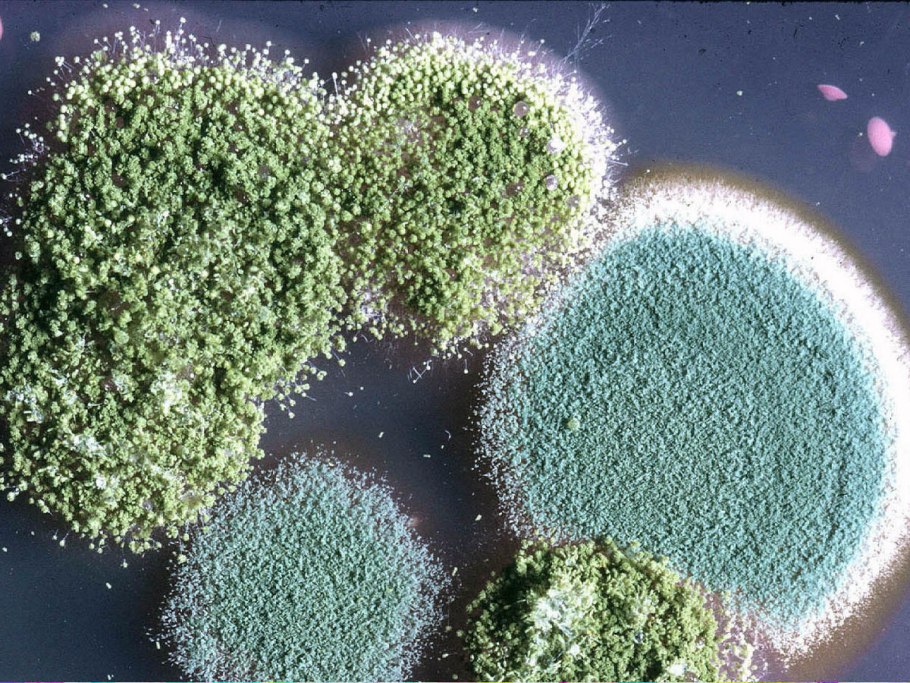

Бурые водоросли дрожжи цианобактерии

Водоросли их многообразие

Бурые водоросли Тип питания

Оксифотобактерии бактерии это

Одноклеточные колониальные и многоклеточные водоросли

Rivularia водоросль

Цианобактерии Анабена

Цианобактерии класс

Состав водорослей

Эоархей цианобактерии

Синезеленые водоросли цианобактерии

Кладофора микроскоп

Водоросли доклад 3 класс морская капуста

Бактерии и цианобактерии

Микроводоросль спирулина

Носток цианобактерия

Зигомицеты микробиология

Spirulina микроскоп

Прокариоты цианобактерии

Цианобактерии осциллатория

Цианобактерии формула

Цианеи водоросли

Автлтрофные олноклеточнеы организсы

Зеленые водоросли вольвокс

Спирогира в микроскопе

Одноклеточная харовая водоросль

Синехоцистис водоросль

Cladophora клетка

Сине-зеленые водоросли цианобактерии

Жизненный цикл морской бурой водоросли

Microalgae Journal

Цианобактерии спирулина

Unicellular Green algae

Фукус микроскоп

Цианобактерии Arthrospira

Токсичные водоросли

Биология 7 класс бесполое размножение хламидомонады

Анабена классификация

Ульва поперечный срез
Отдел сине-зеленые водоросли (Cyanophyta)

Цианеи сине зеленые водоросли

Цианобактерии Microcoleus

Хлорелла цианобактерии

Осилотория под микроскопом

Вошерия (Vaucheria)

Полисифония водоросль

Строение бактериальной клетки прокариот

Кладофора водоросль микроскоп

Пальмеллоидный таллом

Водоросли макроцистис и хлорелла

Цианобактерии морфологические особенности

Aspergillus и Penicillium

Элодея канадская под микроскопом

Пальмелоидные водоросли

Цианобактерии в чашке Петри

Спирогира водоросль

Поделиться фото в социальных сетях:
Комментариев (0)
Похожие фото:











